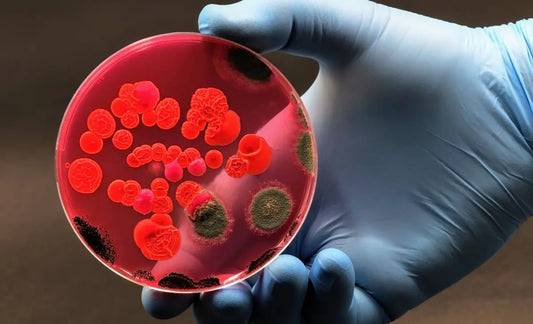

Discoveries
The rebellion of the antibiotic-resistant super...
Dennis de Beeld
Author: Liliana Sánchez Rocha Read time: 7 minutes This tale warns us about an emerging danger that has been simmering for nearly a century: the rise of a new generation...
The rebellion of the antibiotic-resistant super...
Dennis de Beeld
Author: Liliana Sánchez Rocha Read time: 7 minutes This tale warns us about an emerging danger that has been simmering for nearly a century: the rise of a new generation...
Check out the game
-
Aanbieding
ImmunoWars Combo Pack
Verkoper:ImmunoWarsNormale prijs €49,99 EURNormale prijsEenheidsprijs / per€54,99 EURAanbiedingsprijs €49,99 EURAanbieding -
ImmunoWars Base Game
Verkoper:ImmunoWarsNormale prijs €39,99 EURNormale prijsEenheidsprijs / per -
ImmunoWars STD Booster Pack
Verkoper:ImmunoWarsNormale prijs €14,99 EURNormale prijsEenheidsprijs / per
1
/
van
3